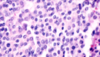

Pituitary Path Flashcards
(12 cards)
most common type of pituitary tumor
prolactinoma
craniopharyngioma
arises in children from embryological remnant of Rathke’s pouch
can cause panhypopituitarism
post-partum pituitary necrosis
Sheehan’s syndrome
pituitary infection –> necrosis and atrophy –> acute panhypopituitarism –> lack of cortisol can lead to death –> if survived, can get chronic panhypopituitaryism –> end organ atrophy
which cells in pituitary make what?
somatotrophs GH
lactotrophs prolactin
corticotrophs ACTH
gonadotrophs FSH, LH
thyrothrophs TSH
acidophils and basophils in pituitary
acidophils: somatrophs and lactotrophs
basophils: corticotrophs, gonadotrophs, thyrotrophs
what is this?

normal anterior pituitary w/ acidophils, basophils, chromophobes
what is this?

corticotrophs in normal pituitary
what is this?

pituitary adenoma - monomorphic w/ acidophils, lacking normal architecture
what is this
pituitary adenoma - chromophobe
what is this?

craniopharyngioma - shows cysts

craniopharyngioma

craniopharyngioma